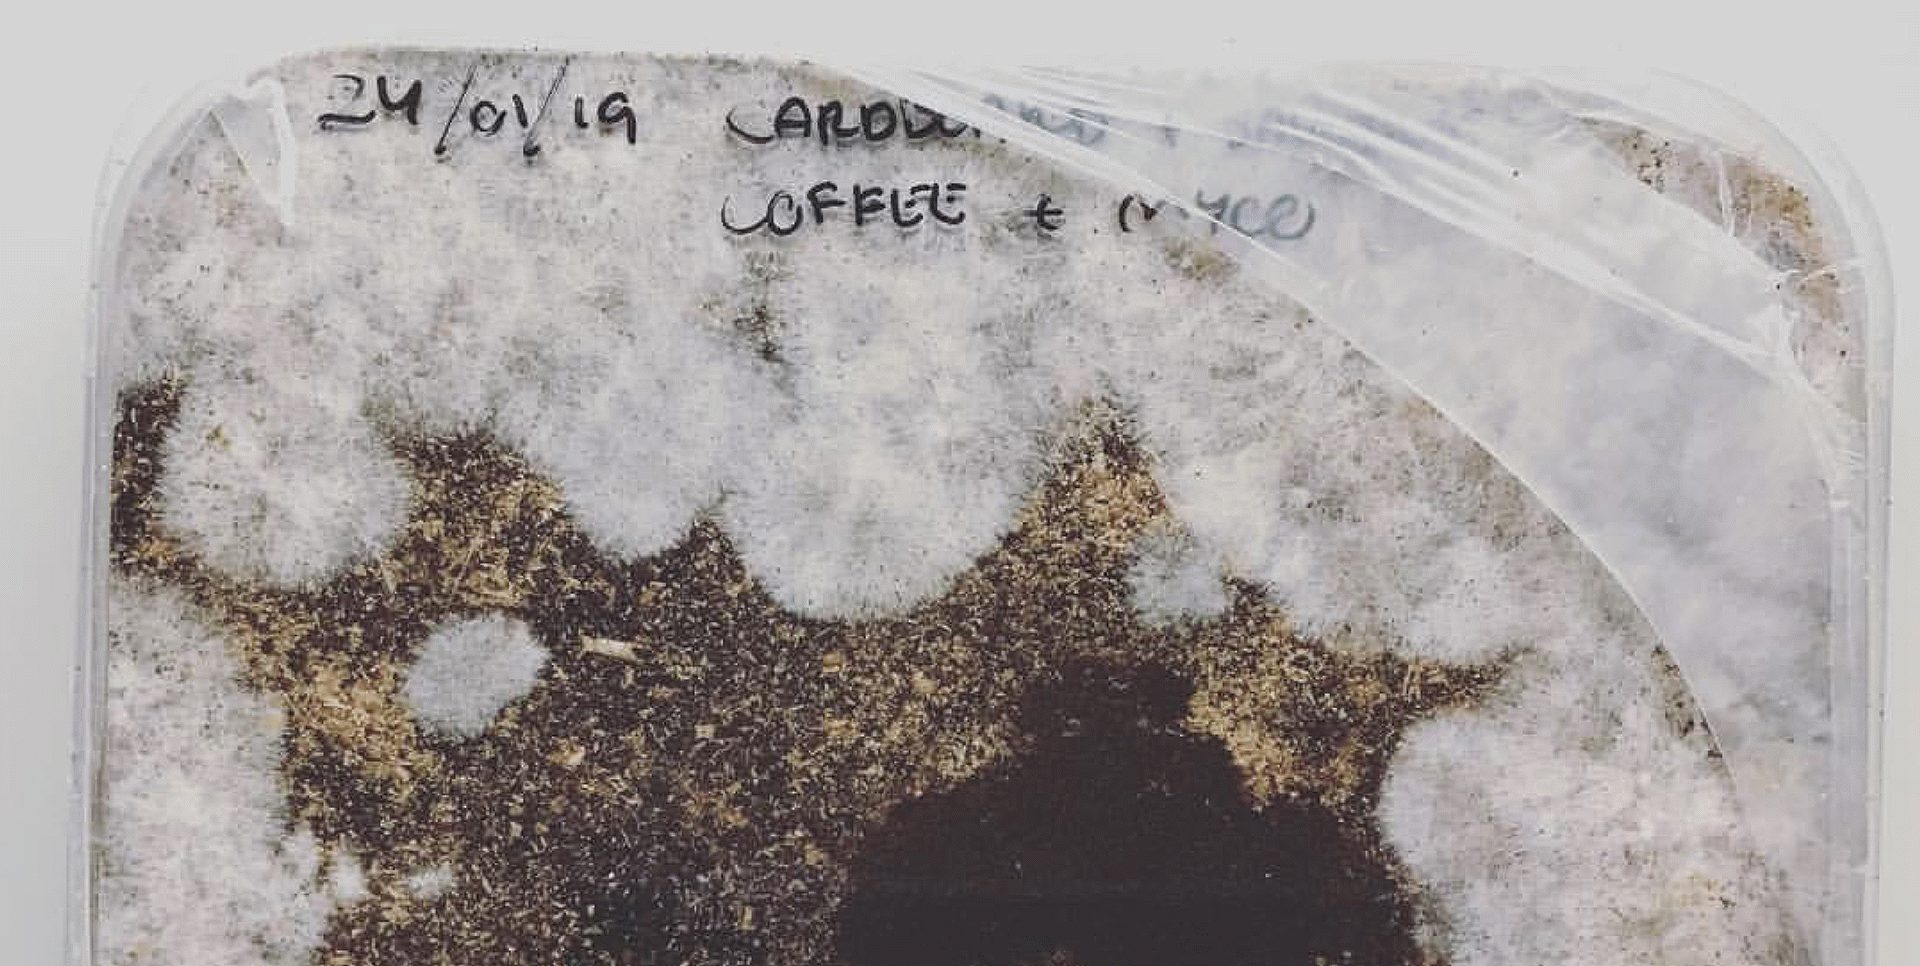
Materialitats emergents

Materialidades emergentes es un curso experimental centrado en la exploración de materiales naturales infrautilizados —madera, resina, ailanto y micelio— y en sus posibilidades de transformación. Integrando ciencia de materiales, saberes artesanales, diseño regenerativo e investigación artística, el curso promueve soluciones orientadas a la sostenibilidad, basadas en la comprensión del papel activo que la materia desempeña en el entramado ecológico.
→ Del 8 de octubre de 2025 al 21 de enero de 2026
→ Eina Bosc
→ Regístrate al programa completo (4 módulos)
→ Regístrate 1 material (1 módulo)
Si formas parte de la comunidad EINA, aprovecha un 15% de descuento introduciendo el código MATERIALIDADES2025 el momento de la inscripción.
El curso está pensado para todas aquellas personas interesadas en explorar los materiales del futuro desde una perspectiva crítica, creativa y situada. Se dirige especialmente a:
- Diseñadores, artistas, arquitectos y creadores que buscan repensar su relación con los materiales y abrir nuevas formas de experimentación.
- Estudiantes y profesionales vinculados al arte, el diseño, la arquitectura, la sostenibilidad o la ciencia de materiales, que deseen integrar una mirada ecológica, ética y transdisciplinar en su práctica.
- Investigadores y educadores interesados en metodologías de aprendizaje experimental, pensamiento postnatural o participación comunitaria.
- Personas comprometidas con la transición ecosocial, con ganas de explorar maneras más responsables y colaborativas de producir, habitar y transformar el entorno.
El curso combina investigación, laboratorios prácticos, prototipado y espacios de reflexión colectiva. Su estructura se organiza en módulos temáticos que abordan dos ejes principales: el potencial de regeneración y transformación de materiales residuales, y la creación de ensamblajes híbridos mediante la integración de organismos vivos con estructuras inertes. Cada módulo incluye:
- Encuentros introductorios en el Parque de Collserola que combinan el conocimiento técnico de los materiales con herramientas críticas para orientar su exploración.
- Talleres experimentales donde se manipulan y transforman los materiales en colaboración con especialistas invitados.
- Espacios de intercambio y diálogo colectivo, donde se comparten procesos, aprendizajes y preguntas.
Madera muerta
Miércoles 8 y 15 de octubre · 17:00 – 21:00 h
Jordi Vayreda (CREAF) y Cris Noguer
Resina
Miércoles 12 y 19 de noviembre · 17:00 – 21:00 h
Maria Dolors Grau Vilalta (UPC), Forest Baix y Lara Campos
Micelio
Miércoles 10 y 17 de diciembre · 17:00 – 21:00 h
TBC y Ona Orozco + Jessica Dias
Ailanto
Miércoles 14 y 21 de enero · 17:00 – 21:00 h
Cesc Balanzó y Julia Steketee
Lara Campos, investigadora de materiales, diseñadora y artista multidisciplinar.
Ona Orozco, Diseñadora de producto e investigadora independiente especializada en nuevas materialidades.
Jessica Dias, biodiseñadora e investigadora, cofundadora de @bio.babes y de @s__biotica.
Forest Baix, cooperativa dedicada a la resinación, gestión forestal sostenible y transformación de la madera en el ámbito local.
Cris Noguer, diseñadora e investigadora independiente, con el foco en innovaciones y transformación para futuros ecológicamente sostenibles.
Julia Steketee, diseñadora, artista y artesana. Su investigación se centra en materiales locales, biobasados y derivados de residuos.
Programa completo 4 materiales: 625 €
Programa 1 material: 168 €
15% de descuento para la comunidad Eina.
Descuentos
*Tendrás un 15% de descuento en los siguientes cursos como beneficio por formar parte de la comunidad Eina.
*Si traes a otra persona, tendréis un 10% de descuento en el curso. Contacta con eina.obra@eina.cat
para obtener el código personalizado.
Becas
Eina Obra cuenta con un programa de talento y ofrece una beca del 100% del precio del curso para cada programa.
Para participar, envíanos un correo electrónico a eina.obra@eina.cat deberás enviar tu portafolio/CV y una carta de motivación.
Miércoles 8 y 15 de octubre · 17:00 – 21:00 h
Sesión 1 · Usos funcionales con mínima transformación
Exploración de usos directos y estructuras simples a partir de madera muerta, con una mirada sostenible y de bajo impacto.
Con Jordi Vayreda y Cris Noguer.
Sesión 2 · Biocomposites con serrín, fibras y ligantes naturales
Fabricación de materiales moldeables y resistentes a partir de residuos de madera, fibras vegetales y aglutinantes de origen natural.
Con Cris Noguer.
Miércoles 12 y 19 de noviembre · 17:00 – 21:00 h
Sesión 1 · Materialidades y biocompuestos
Creación de láminas reutilizables elaboradas con resina de pino, ceras y aceites, como alternativa biodegradable a los plásticos convencionales.
Con Maria Dolors Grau Vilalta, Forest Baix y Lara Campos.
Sesión 2 · Láminas prensadas
Elaboración de materiales duros y compostables, adecuados como soportes creativos, a partir de resina natural y serrín.
Con Lara Campos.
Miércoles 10 y 17 de diciembre · 17:00 – 21:00 h
Sesión 1 · Micelio estructural
Exploración del micelio como material de construcción viva, atendiendo a sus tiempos de crecimiento, cuidados específicos y posibilidades en estructuras sólidas y autoformadas.
Con TBC y Ona Orozco + Jessica Dias.
Sesión 2 · Micelio blando o híbrido
Trabajo con texturas más suaves y combinaciones de micelio con otros materiales, orientadas a usos flexibles y experimentales.
Con Ona Orozco + Jessica Dias.
Miércoles 14 y 21 de enero · 17:00 – 21:00 h
Sesión 1 · Extracción de fibras para hilos, cuerdas o refuerzos
Investigación del potencial del ailanto como recurso textil, extrayendo sus fibras y explorando sus aplicaciones en refuerzo estructural y tejido.
Con Cesc Balanzó y Julia Steketee.
Sesión 2 · Láminas prensadas
Creación de superficies moldeables y compostables a partir de material vegetal recolectado, experimentando con procesos manuales y de prensado.
Con Julia Steketee.